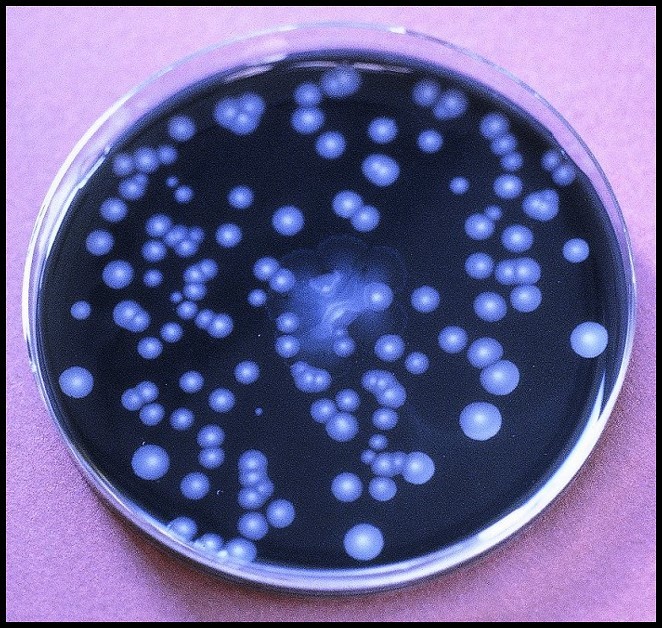

Legionella pneumophilia is a gram _____ _____
Gram negative bacilli
What virulence factor of L. pneumophilia induces a macrophage to take it up by coiling phagocytosis?
Mip (Macrophage infectivity promoter)
What two virulence factors of L. pneumophilia disturb acidification of the phagosome, prevent lysosomal fusion and take over organelle trafficking to provide nutrients, ultimately making a nice home for the organism out of a phagosome?
L. pneumophilia produces _____ to help it spread through tissues.
Metalloproteases
L. pneumophilia produce _____ and _____ to help it get out of the phagosome when ready
Hemolysins and phospholipases
L. pneumophilia is ubiquitous in what kind of environments?
Fresh water
L. pneumophilia is notorious for living in what household appliance?
Air conditioning cooling towers
How is L. pneumophilia acquired?
Via aerosolization and subsequent inhalation
Legionella, once inhaled, is covered in C3b then, enter macrophages through _____ or _____ phagocytosis

What two groups are at risk for L. pneumophilia infection?
The initial symptoms of Legionnaire’s disease that occur
2-10 days after exposure are _____. They can progress to a _____ pneumonia.
The necrotizing pneumonia of advanced Legionnaire’s disease deomonstrates _____ consolidation, _____, and a “_____” appearance

_____ is a milder form of Legionnaires that presents with similar flu-like symptoms, but WITHOUT _____
Pontiac Fever presents similarly to Legionnaire’s, but WITHOUT PNEUMONIA
T/F Pontiac Fever requires antibiotics
FALSE
There is a spontaneous cure about 2-5 days after illness
Antigen for the L. pneumophilia serogroup 1 can be found in _____
Urine
What kind of medium does L. pneumophilia grow on?
BCYE (Buffered charcoal yeast extract)
Look how pretty:
Assessing the _____ for presence of L. pneumophilia is not a good option.
What stains are used to diagnose L. pneumophilia infetion?
What treatment options are available for Legionnaire’s Disease?